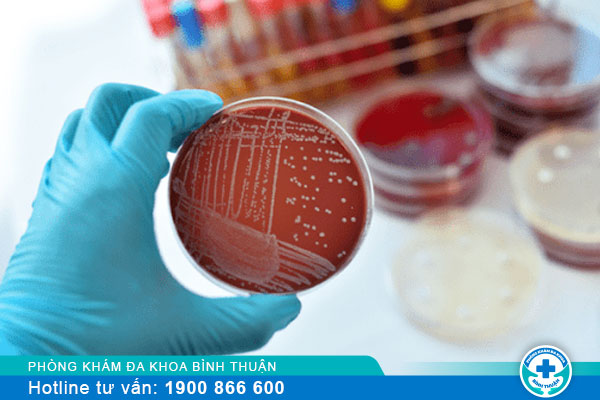

Bệnh lậu ở nam giai đoạn đầu có biểu hiện gì?
Cho số những căn bệnh xã hội nguy hiểm thì bệnh lậu được xem là căn bệnh phổ biến có khả năng gây ra những ảnh hưởng nghiêm trọng đến cuộc sống và sức khỏe. Phát hiện bệnh càng sớm thì việc hỗ trợ điều trị bệnh cảm mang lại hiệu quả. Nam giới có thể tham khảo những chia sẻ chi tiết dưới đây để phát hiện được bệnh lậu ở nam giai đoạn đầu nhé.
THÔNG TIN VỀ BỆNH LẬU
Lậu là căn bệnh xã hội phổ biến chủ yếu lây nhiễm thông qua các hoạt động tình dục không có biện pháp an toàn. Căn bệnh này được gây ra bởi loại vi khuẩn có tên khoa học đó là Neisseria gonorrhoeae. Căn bệnh này có thể mắc ở cả nam và nữ, xuất hiện phổ biến ở nam nữ trong độ tuổi sinh sản.
Đây là căn bệnh xã hội nên khả năng lây nhiễm căn bệnh này rất cao và căn bệnh có thể dẫn đến những biến chứng rất nghiêm trọng cho sức khỏe. Vi khuẩn lậu có khả năng gây nhiễm trùng cho rất nhiều cơ quan của cơ thể như cổ họng, bộ phận sinh dục, trực tràng,... Vậy làm sao có thể nhận biết được bệnh lậu ở nam giai đoạn đầu để chủ động đi thăm khám?

BỆNH LẬU Ở NAM GIỚI ĐOẠN ĐẦU NHƯ THẾ NÀO?
Nam giới sẽ bắt đầu xuất hiện các triệu chứng của bệnh lậu sau khi bị nhiễm vi khuẩn lậu khoảng 2 ngày và có một số trường hợp có thể kéo dài lâu hơn. So với nữ giới thì biểu hiện về lậu ở nam giới sẽ có thể thấy rõ ràng hơn. Ở một số trường hợp nam giới sẽ không xuất hiện các triệu chứng rõ ràng nhưng vẫn sẽ có khả năng lây nhiễm. Thường triệu chứng bệnh lậu ở nam giới sẽ có biểu hiện rõ rệt sau khoảng một tuần:
Viêm niệu đạo
Viêm niệu đạo được xem là triệu chứng phổ biến của nam giới khi mắc bệnh lậu. Tình trạng này thường xảy ra nếu nam giới quan hệ tình dục thông qua đường âm đạo đối với người bệnh và các triệu chứng thường gặp là:
♦ Bị phù nề và sưng đỏ ở miệng sáo
♦ Đi tiểu buốt và có mủ với số lượng nhiều, có màu vàng hoặc màu xanh,...
♦ Tiểu khó, tiểu rắt và có thể tiểu ra máu cuối bãi
♦ Tình trạng nóng buốt có thể ngày một gia tăng
Nhiễm trùng ở trực tràng, hậu môn
Tình trạng này thường hay xảy ra đối với nam giới có hoạt động quan hệ đồng tính nam. Và sẽ xuất hiện một số các triệu chứng sau đây:
♦ Ngứa ngáy ở hậu môn
♦ Hậu môn sẽ có dịch mỗi ngày nhưng thường không có cảm giác đau
♦ Soi hậu môn có thể thấy phù nề và đỏ
♦ Thỉnh thoảng có thể xảy ra hiện tượng trực tràng bị chảy máu
♦ Bị viêm trực tràng với các biểu hiện như mót rặn, tiêu chảy, táo bón và đi ngoài có dịch mủ,...

Nhiễm trùng hầu họng
Đây là tình trạng bệnh lậu ở nam giới giai đoạn đầu khi có quan hệ đồng giới hoặc quan hệ tình dục thông qua đường miệng. Với triệu chứng như sau:
♦ Viêm amidan
♦ Miệng có xuất hiện các nốt nhiệt
♦ Bị viêm họng cấp với biểu hiện ngứa họng, đau họng, đỏ họng,...
♦ Ở cổ có thể bị sưng hạch
♦ Xuất hiện tình trạng sốt
Ngoài ra nam giới khi bị bệnh lậu ở giai đoạn đầu còn có khả năng dẫn đến nhiễm trùng cho nhiều cơ quan khác. Một số trường hợp phát hiện bị viêm kết mạc mắt, bị nhiễm trùng da ở cơ quan sinh dục hay ngón tay, mông,...
NGUY HIỂM NẾU KHÔNG CAN THIỆP BỆNH LẬU Ở NAM GIAI ĐOẠN ĐẦU
Nam giới nếu không phát hiện dấu hiệu sớm để can thiệp hỗ trợ điều trị thì có thể gây ra những hậu quả nặng nề như sau:
⇒ Viêm niệu đạo, viêm đường tiết niệu, hẹp niệu đạo, viêm bàng quang và có thể là viêm tuyến tiền liệt.
⇒ Bị viêm tinh hoàn, teo tinh hoàn, viêm túi tinh và ảnh hưởng đến hoạt động tình dục cũng như chức năng sinh sản.
⇒ Trường hợp nặng hơn có khả năng gây ung thư tinh hoàn.
⇒ Xuất hiện tình trạng mủ ở cơ quan sinh dục và làm đau nhức vùng bẹn.
⇒ Có nguy cơ cao hơn trong việc mắc phải hội chứng suy giảm miễn dịch hiv/aids.
⇒ Tăng khả năng lây nhiễm cho bạn tình nếu quan hệ không an toàn
Vậy nên nam giới cần biết bệnh lậu ở nam giai đoạn đầu như thế nào để chủ động hơn trong việc thăm khám, phát hiện và hỗ trợ điều trị bệnh. Nam giới cần chú ý rằng việc phát hiện bệnh lậu càng sớm thì việc hỗ trợ điều trị càng mang lại hiệu quả. Và quan trọng là bạn phải biết lựa chọn cơ sở y tế uy tín và chất lượng.
Hiện nay nếu như bạn vẫn còn phân vân chưa biết lựa chọn cơ sở nào để thăm khám thì có thể chọn Phòng Khám Đa Khoa Phú Thủy Phan Thiết nằm ngay 04 Nguyễn Gia Tú, Phú Thuỷ, Tp. Phan Thiết, Bình Thuận. Nếu lựa chọn cơ sở này thì bệnh nhân hoàn toàn có thể yên tâm vào các yếu tố chất lượng sau đây:
► Đây là phòng khám có chuyên môn trong việc khám và hỗ trợ điều trị các bệnh xã hội do Bộ Y tế cấp phép hoạt động.
► Các bác sĩ khi làm việc tại phòng khám đều có năng lực chuyên môn tốt, kinh nghiệm vững vàng và thấu hiểu tâm lý người bệnh.
► Người bệnh cũng không cần lo lắng về quy trình khi có nhân viên y tế đã túc trực hướng dẫn cụ thể.
► Các phương án để khám, xét nghiệm chẩn đoán và hỗ trợ điều trị đều áp dụng bằng hệ thống máy móc y khoa hiện đại.
► Thông tin cá nhân của người bệnh luôn được bảo mật và đặc biệt bệnh nhân có thể yên tâm vì không gian khám bệnh sẽ thiết kế từng phòng bệnh khám riêng.
► Phòng khám có sự đầu tư về cơ sở vật chất khi các phòng bệnh đều được trang bị đầy đủ tiện nghi để mang đến kết quả hỗ trợ điều trị khả quan.
► Bệnh nhân yên tâm khi không cần phải xếp hàng chờ đợi thăm thẳm mà có thể đặt lịch từ trước và cũng không cần lo lắng sẽ ảnh hưởng công việc khi phòng khám hỗ trợ ngoài giờ.
► Để mang đến chất lượng dịch vụ y tế tốt thì phòng khám cũng xây dựng đội ngũ tư vấn viên trực tuyến 24/7 để sẵn sàng tiếp nhận và giải quyết các vấn đề của bệnh nhân khi chưa thể đến phòng khám trực tiếp.
► Mức chi phí chi trả cho việc xét nghiệm và hỗ trợ điều trị bệnh xã hội như bệnh lậu luôn được phòng khám công khai với mức chi phí cụ thể.
Những thông tin trên đây của chúng tôi hi vọng và giúp nam giới xác định được dấu hiệu bệnh lậu ở nam giai đoạn đầu để sớm đi thăm khám và hỗ trợ trong việc điều trị. Đừng chủ quan khi cơ thể mình bắt đầu cảnh báo những dấu hiệu bất thường. Mọi ý kiến thắc mắc liên quan đến bệnh xã hội nhưng bệnh nhân chưa thể trực tiếp đến phòng khám thì hãy sớm liên lạc đến địa chỉ hotline 0252 7303 888 hoặc có thể nhắn tin vào ô chat bên dưới sẽ luôn có tư vấn viên giúp đỡ.